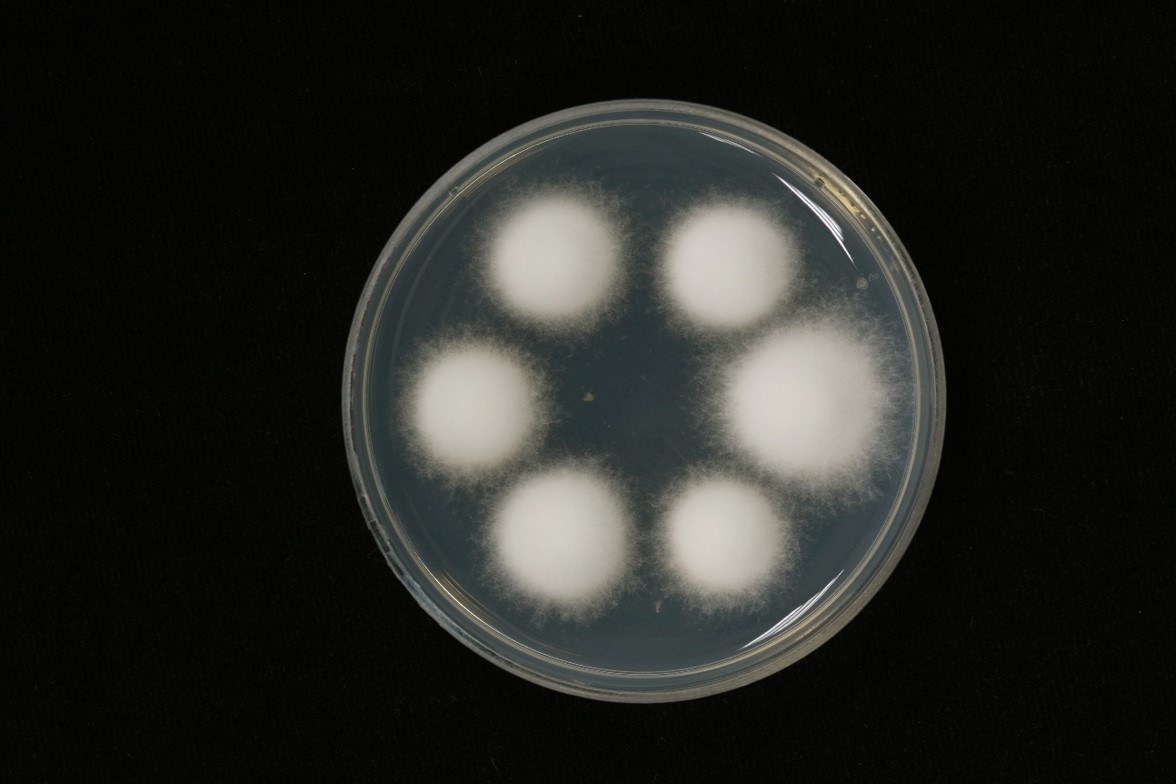

Holotype:
THAILAND, Nakhon Ratchasima Province, Khao Yai National Park, 1 Jun. 2011, K. Tasanathai, P. Srikitikulchai, S. Mongkolsamrit, A. Khonsanit, K. Sansatchanon, W. Noisripoom, holotype BBH 31439, ex-type living culture BCC 47975.
Habitat:
Underside of a dicotyledonous leaf.
Host:
On Portia sp.
Description:
White to grayish- or brownish-white mycelial mat velvety, completely covering the  spider host, firmly attaching the underside of living leaf by the mycelia covering its legs.
spider host, firmly attaching the underside of living leaf by the mycelia covering its legs.  Synnema solitary, arising from the posterior of the host abdomen, cylindrical, consisting of a compact bundle of parallel hyphae, 15–20 mm long with blunt tip. Conidiophores arising laterally from synnema, stout, smooth, mostly biverticillate, 20–30 × 4 µm. Vesicles absent or hardly developed, bearing multiple metulae. Metulae obovoid, slightly broadening toward the base, 7–15 × 2–7 µm. A number of phialides borne on each metula, broadly cylindrical, abruptly tapering toward the apex, forming thickened distinct short neck, 9–14 × 2–4 µm, each bearing a conidium. Conidia fusiform, 5–9 × 1.5–3 µm. Sexual morph occasionally present.
Synnema solitary, arising from the posterior of the host abdomen, cylindrical, consisting of a compact bundle of parallel hyphae, 15–20 mm long with blunt tip. Conidiophores arising laterally from synnema, stout, smooth, mostly biverticillate, 20–30 × 4 µm. Vesicles absent or hardly developed, bearing multiple metulae. Metulae obovoid, slightly broadening toward the base, 7–15 × 2–7 µm. A number of phialides borne on each metula, broadly cylindrical, abruptly tapering toward the apex, forming thickened distinct short neck, 9–14 × 2–4 µm, each bearing a conidium. Conidia fusiform, 5–9 × 1.5–3 µm. Sexual morph occasionally present.  Perithecia occurring on the mycelial mat covering the host legs, occasionally on synnema particularly at base, superficial, mostly arranged in groups, ovoid, reddish yellow or light honey-brown, one-third immersed in the loose network of mycelia, 750–870 × 310–380 µm.
Perithecia occurring on the mycelial mat covering the host legs, occasionally on synnema particularly at base, superficial, mostly arranged in groups, ovoid, reddish yellow or light honey-brown, one-third immersed in the loose network of mycelia, 750–870 × 310–380 µm.  Asci over 550 µm in length, 3–7 µm in width, ascus tip 4–5 × 3–4 µm. Ascospores often breaking into part-spores. Part-spores bacilliform, 9–22 × 1.5–2 µm. Granulomanus-like asexual morph absent.
Asci over 550 µm in length, 3–7 µm in width, ascus tip 4–5 × 3–4 µm. Ascospores often breaking into part-spores. Part-spores bacilliform, 9–22 × 1.5–2 µm. Granulomanus-like asexual morph absent.
Culture characteristics:
Colonies on PDA slow-growing, attaining a diam of 1.5 cm in 4 weeks at 25 °C, floccose, forming irregular margin, white, reverse cream, darkening toward center with age. Sporulation occurring after 3-4 months with the absence of synnema, forming a group of conidiophores, grey and scatter. Conidiophores biverticillate. Vesicles absent or hardly developed. Metulae obovoid, 10–16 × 3–7 µm, each bearing cylindrical phialides, 10–16 × 3–4 µm.
Colonies on PDA slow-growing, attaining a diam of 1.5 cm in 4 weeks at 25 °C, floccose, forming irregular margin, white, reverse cream, darkening toward center with age. Sporulation occurring after 3-4 months with the absence of synnema, forming a group of conidiophores, grey and scatter. Conidiophores biverticillate. Vesicles absent or hardly developed. Metulae obovoid, 10–16 × 3–7 µm, each bearing cylindrical phialides, 10–16 × 3–4 µm.  Conidia fusiform, 5–7 × 3–4 µm.
Conidia fusiform, 5–7 × 3–4 µm.
Reference:
Kuephadungphan W, Tasanathai K, Petcharad B, et al. (2020). Phylogeny- and morphology-based recognition of new species in the spider-parasitic genus Gibellula (Hypocreales, Cordycipitaceae) from Thailand. MycoKeys72: 17–42.
DOI: https://doi.org/10.3897/mycokeys.72.55088Species |
Strain |
Compound |
Pubchem CID |
Biological activity |
Reference |
|---|
|
Strain |
ITS | LSU | RPB1 | RPB2 | TEF1 |
|---|---|---|---|---|---|
| BCC 13020 | MT477073 | MH394686 | MH521814 | - | MH521901 |
| BCC 43298 | MT477074 | MH394677 | MH521816 | MH521858 | MH521900 |
| BCC 45127 | MT477075 | - | - | - | MT503332 |
| BCC 47514 | MT477076 | - | - | - | MT503333 |
| BCC 47530 | MT477077 | MT477065 | - | MT503338 | MT503334 |
| BCC 47976 | MT477078 | MT477066 | MT503325 | MT503339 | MT503335 |